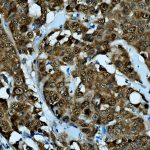

|
|---|
 Anti-Arginase 1 Anti-Arginase 1Buy here |
 Anti-Arginase 1, Clone [C-2] Anti-Arginase 1, Clone [C-2]Buy here |
 Anti-ATRX, Clone D-5 Anti-ATRX, Clone D-5Buy here |
 Anti-AuroraB Anti-AuroraBBuy here |
 Anti-AuroraB Anti-AuroraBBuy here |
 Anti-B Cell Anti-B CellBuy here |
 Anti-B Lymphocyte Antigen 36, BLA-36 Anti-B Lymphocyte Antigen 36, BLA-36Buy here |
 Anti-BAP1 Anti-BAP1Buy here |
 Anti-Basic Fibroblast Growth Factor (bFGF) Anti-Basic Fibroblast Growth Factor (bFGF)Buy here |
 Anti-Bax Protein Anti-Bax ProteinBuy here |